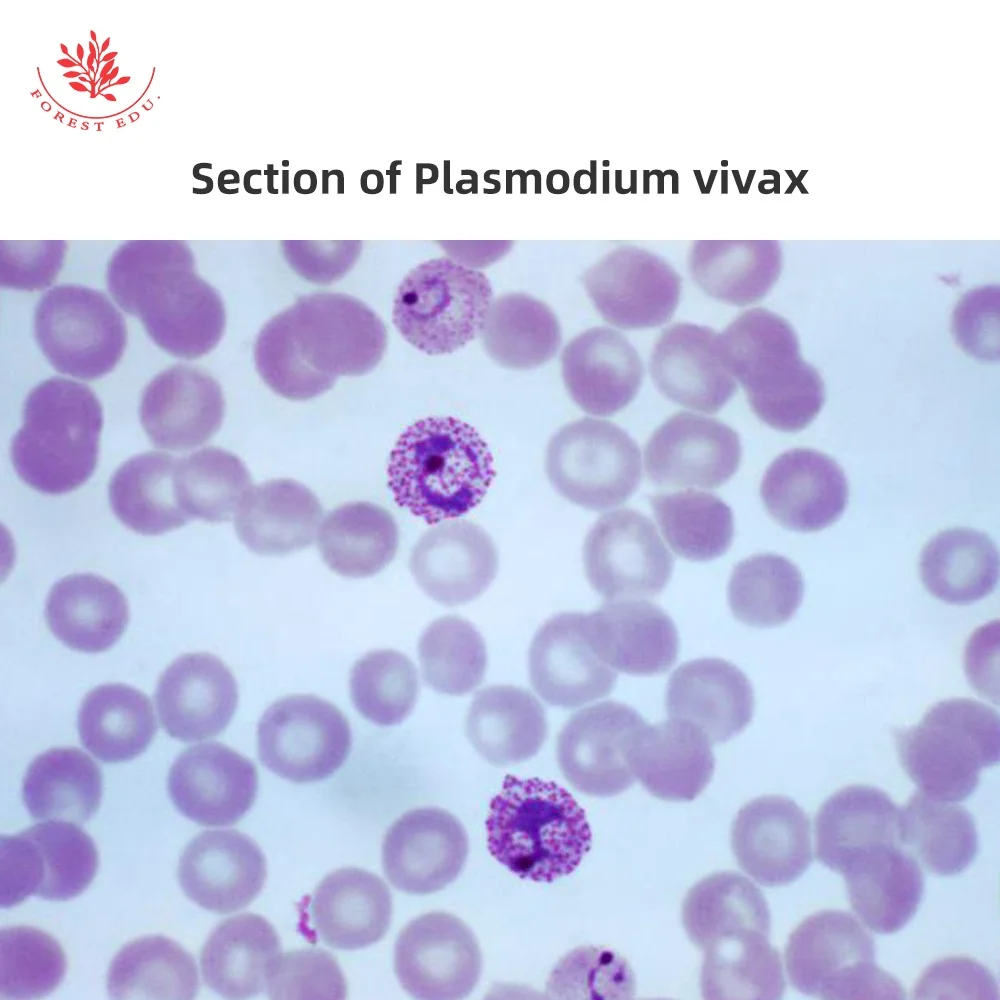
Биологический эксперимент использование микроскопов лабораторий профессиональный Медицинский микроскоп слайды

Биологический эксперимент использование микроскопов лабораторий профессиональный Медицинский микроскоп слайды
- Категория товара: Lab Supplies >>>
- Поставщик (Оптовый магазин): Xinxiang,Red,Forest,Edu.,Instrument,Co.,Ltd.
Поделиться:
Описание и отзывы
Характеристики
Biology Experiment Use Microscope Slides Laboratory Professional Medical Microscope Slides Plasmodium Microscope Slides





| 1.Plasmodium | 2.Plasmodium vivax section |
| 1.Warm service ,proffesional reply . |
| 2.100% Direct factory . |
| 3.We specialize in Teaching and lab equipment manufacture . |
| 4.We could make from raw material to finished product. |
| 5.OEM &ODM is our strong point . |
| 6.We have many years of logistics partners, convenient transportation |
We support a lot of transportation ways, transportation by sea, by air and by train, and other international logistics express. If you want to choose other transportation, contact us, we'll try our bset to fulfill your requirment.
Payment Methods:
1.AliExpress supports Alipay, Visa, MasterCard, Maestro Debit Card, Western Union, Bank Transfer.
2.Please be assured your payment is safely kept by AliExpress until you confirm the delivery of your order.
Packaging & Delivery:
Packaging detail:

2. Products will be shipped ASAP after receiving the payment.
-------------------------------------------------------------
> Delivery Date:
3-10 working days by UPS/DHL/FEDEX;
7-15 working days by EMS.
Others shipment methods depends on your country.
Xinxiang Red Forest Educational Instrument Co.,Ltd is located in the center of China (near to Zhengzhou) Xinxiang city, the city is a factory place for trading.
Our company is focus on Medical model, Prepared slides specimen, Chinese herbal specimen for a long time. We have our experienced 50 years old technicians and energetic 20-30 years old after effect operator. We also have 10 years + export manager to point the direction in the international market.
Based on industry and Domestic & international trade integration, we can supply you a good price and fast service. I sincerely hope that whichever product won't let you down. Thank you for choosing us.






1.Can we(I) buy online ?
Yes you can buy it directly on alibaba by Tradeassurance.
2.Is my money safe if I buy from online?
Of course, Alibaba is the biggest B2B website in China, it take strictly measures to guarantee buyers interests,
if you get the wrong products or bad quality products not as descriped,you could claim.
3.May I know the MOQ ?
1 piece per item, and you could mix different items for your convenience. And some product if you can not make order directly from the website.Please just ask our service people.
4.I'm a personal buyer,do you support small order with many items?
Yes ,of course we do. No problem.
5.Could you give me better price?
We would like to give you our best price generally ,and we have promotion usually.
6. Will my money be refunded if you sent is not I want?
OK, we would like to refund if you show the evidence to proof that it was caused by our faults.
7. What's the courier you often use to deliver the small parcels ?
We use EMS or DHL to ship the goods to you usually when the quantity is not big.
Joey Jiao
Xinxiang Red Forest Edu. Instrument Co.,LTD
QQ: 2648443679
Mobile :0086-17630262870
WeChat QR Code: